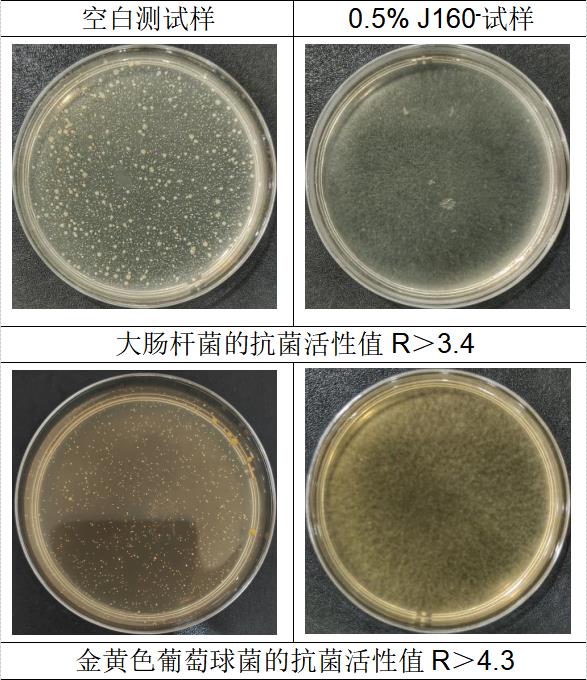

加载更多
加载更多
加载更多
2021-08-26
KEPUYINⓇ J160透明有机抗菌剂属于协同增效型抗菌剂,采用的原料为强效型杀菌剂,其对常见霉菌、真菌和细菌具有很强的杀灭作用。

KEPUYINⓇ J160透明有机抗菌剂属于协同增效型抗菌剂,采用的原料为强效型杀菌剂,其对常见霉菌、真菌和细菌具有很强的杀灭作用。
透明有机抗菌剂的应用
KEPUYINⓇ J160在广泛的油性涂层和透明塑料制品中具有良好的应用,主要用于油性的产品抗菌作用。其应用领域包括: - 浴帘 - 吸尘器部件 - 垃圾桶 - 床上用品- 聚氨酯制品 - 空气过滤器- 油性涂料 - 人造丝- 遮阳篷- 帐篷- 呼吸器面具组件 - 浴缸和浴缸外壳- 丙烯腈-丁二烯-苯乙烯等领域其具有广谱杀微生物活性。
抗菌特性
KEPUYINⓇ J160 透明有机抗菌剂预防问题微生物生长所需的产品剂量列于表 1 中。
最低抑菌浓度(MIC)不代表实际使用剂量,但是能显示出 KEPUYINⓇ J160的广谱活性。
* 协同增效,抗菌谱宽,尤其对真菌,多数革兰氏阳性菌和革兰氏阴性菌有特效;
* 便于使用,容易分散均匀;
* 超强抗菌,低添加量
* 规定使用量下,对人体无刺激,无毒,符合REACH和EPA法规;
* 适用的pH范围广泛,2-12均可使用;
* 耐高温290℃、耐老化、耐黄变、不挥发、抗流失;
* 不影响材料的物理性能,不影响透明度。
抗菌机理
KEPUYINⓇ J160 属于非特定性杀菌机制,这意味着细菌不易产生抗性。
主要组分先吸附于细菌细胞壁上,进而穿透细胞壁,与细胞质中的脂质、蛋白质反应,导致蛋白质变性,进而杀死细菌;
其他组分作为DNA/RNA合成抑制剂其对多种细菌、霉菌、酵母菌和藻类都有优异的抗菌效果。
如果需要详细的抗菌机理,请联系科普茵。
推荐用量
KEPUYINⓇ J160 建议单独使用,使用前请阅读注意事项,也可以和其他防腐剂复配使用,复配使用建议先小批量试用并和科普茵联系测试其效果。
广泛应用于涂料、塑料和杀菌消毒等领域,用贴膜法试验和使用效果,大量的数据显示 KEPUYINⓇ J160 具有独特的抗菌活性。 在实际应用中KEPUYINⓇ J160 的抗菌活性已经被进一步证实,表 3 中列举了一系列的应用浓度。但是建议对每个应用配方进行相关测试,以此来确认使用剂量具有最佳的性价比。
注意:此产品对黏膜有过敏性,使用时,请穿戴好劳动防护用品。
实际测试结果
KEPUYINⓇ J160按GPPS材料质量的0.5%w/w添加,充分搅拌混合均匀后,挤出成型。剪裁成125px边长的正方形。参考GB/T 21551.2-2010标准进行测试抗菌效果
包装/存储/运输
包装:25kg铁箍纸桶
保存限期:18个月(20℃)
储存:储存在原容器中,避免极端的温度,通风干燥阴凉处储存,注意避光保存。
运输:非危险品,以一般化学品运输。
技术服务
作为客户支持计划的一部份,科普茵的微生物实验室都具备GB,ISO,JIS,ASTM,AATCC等实验项目的能力。如果您需要这些检测的服务,请联系科普茵。

作者:佛山科普茵生物科技有限公司
时间:
浏览: